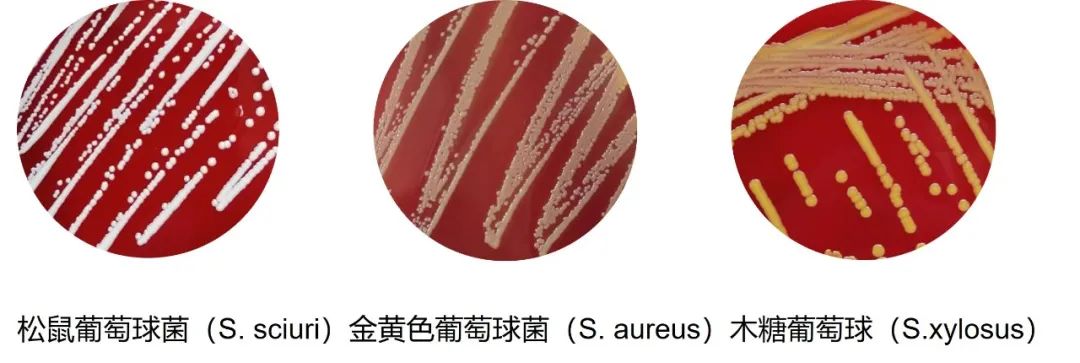
4.jpg

-
2024-8-13
嚙齒動(dòng)物血生化項目分析(下)
-
2024-8-6
小二麻痹癥與百萬(wàn)只猴
-
2024-7-30
非人靈長(cháng)類(lèi)動(dòng)物源的傳染病
-
2024-7-23
實(shí)驗動(dòng)物術(shù)后監測及切口閉合的原則
-
2024-7-16
獸醫流行病學(xué)在規模化猴場(chǎng)疾病防控中的應用
-
2024-7-9
嚙齒動(dòng)物血生化項目分析(上)
-
2024-7-2
實(shí)驗嚙齒動(dòng)物手術(shù)操作的止痛方案考量
-
2024-6-25
混亂的圈養食蟹猴遺傳組成
-
2024-6-18
規模化猴場(chǎng)傳染性疾病防控設想
-
2024-6-11
小鼠肺部插管簡(jiǎn)易方法
金黃色葡萄球菌,“必檢”還是“必要時(shí)檢”?
2023年7月1日實(shí)施的GB14922-2022將金黃色葡萄球菌從SPF級嚙齒動(dòng)物和兔的“必檢項”調整為“必要時(shí)檢測項”,這讓實(shí)驗動(dòng)物設施管理者和獸醫們在制定自己設施的監測項目清單時(shí)有了自由選擇的空間。那么金黃色葡萄球菌在實(shí)驗動(dòng)物中存在的可能性究竟有多少,對動(dòng)物健康和研究有哪些影響,是否要將其從自己設施的監測清單中刪除呢?本文將對金黃色葡萄球菌的基本信息進(jìn)行整理介紹,為讀者朋友們提供參考依據。
病原學(xué)介紹
金黃色葡萄球菌(Staphylococcus aureus)隸屬葡萄球菌屬(Staphylococcus)葡萄球菌科(Staphylococcaceae),該屬除了最廣為人知的金黃色葡萄球菌外還包括木糖葡萄球菌(S.xylosus)、)、松鼠葡萄球菌(S. sciuri)、尼泊爾葡萄球菌(S. nepalensis)等二十余種葡萄球菌。
葡萄球菌屬細菌是革蘭陽(yáng)性球菌,大小約0.5~1.5μm,呈2~4個(gè)細菌或無(wú)規則葡萄狀排列、無(wú)動(dòng)力、無(wú)芽孢、無(wú)鞭毛或形成有限的莢膜。
流行病學(xué)
人、嚙齒類(lèi)動(dòng)物、兔等多種動(dòng)物都是金黃色葡萄球菌的天然宿主,主要通過(guò)直接接觸或間接接觸感染的動(dòng)物、污染物等傳播。在健康人群中,金黃色葡萄球菌的檢出率約為25%。在實(shí)驗動(dòng)物中,由于飼養、管理、種子質(zhì)量等不同,不同的動(dòng)物群體中檢出率會(huì )存在較大差異。
美國CharlesRiver統計從2003-2020年該公司檢測實(shí)驗室接收的小鼠中金黃色葡萄球菌檢出率是2.2%(n=98979),大鼠檢出率是23.6%(n=10413)。歐美幾個(gè)主要實(shí)驗動(dòng)物供應商的監測報告則顯示其小鼠金黃色葡萄球菌檢出情況差別較大,甚至出現同一供應商不同設施或不同級別動(dòng)物檢出率不同的情況。例如CharlesRiver北美和加拿大的無(wú)病毒抗體(VAF)小鼠中檢出率最高,達20.9%, JAX實(shí)驗室標準小鼠中則只有0.8%,其他供應商不同微生物等級小鼠的檢出率從0到9.7%不等(表1)。歐洲的實(shí)驗動(dòng)物設施則參考FELASA的要求,不報告SPF小鼠的金黃色葡萄球菌檢測情況。這些數據表明,在世界范圍內常規SPF實(shí)驗小鼠和大鼠群體中金黃色葡萄球菌都是普遍存在的。不過(guò)由于免疫缺陷動(dòng)物在感染金黃色葡萄球菌后更容易發(fā)展成有癥狀的臨床疾病,因此國外主要供應商無(wú)一例外的都在自己的免疫缺陷動(dòng)物種群中都排除了該菌。詳見(jiàn)表1。
表1 歐美主要供應商不同設施中小鼠金黃色葡萄球菌檢出率

注:a:屏障設施的具體定義由各個(gè)供應商提供,詳細可參考其網(wǎng)站。SPF:無(wú)特定病原體,SOPF:無(wú)特定和機會(huì )性病原體,VAF:無(wú)病毒抗體。 b:數據收集于2016年11月。CharlesRiver,Janvier和Envigo累積數據18個(gè)月、JAX實(shí)驗室12個(gè)月, Taconic 6個(gè)月。 c:根據FELASA的建議未報告金黃色葡萄球菌。
西山生物2022年的檢測數據顯示:我國大鼠中金黃色葡萄球菌有12.56%(n=1 154)的檢出率;而小鼠中檢出率較低,僅有0.28%(n=8 228)。此外,潘金春等報告2013—2015年廣東省實(shí)驗小鼠的金黃色葡萄球菌檢出率為0.7%(n=858),實(shí)驗大鼠的金黃色葡萄球菌檢出率為2.9%(n=104)。這些數據表明我國小鼠中金黃色葡萄球菌感染率較低,但大鼠則要高許多。
對從實(shí)驗小鼠和大鼠中分離到的金黃色葡萄球菌進(jìn)一步分型分析發(fā)現,C88型最常見(jiàn),占54.5%,也有許多人類(lèi)中常見(jiàn)的株型,例如CC1, CC5, CC8, CC15, CC10,CC30等被檢出,合計占比為37.4%。考慮到一個(gè)世紀以來(lái)實(shí)驗小鼠和大鼠與人類(lèi)的密切接觸史,研究者們認為這些菌株最初就是從人類(lèi)傳播給嚙齒類(lèi)動(dòng)物的。但并不是所有適應人類(lèi)的金黃色葡萄球菌都能在嚙齒類(lèi)群體中定植。例如CC30和CC45在人類(lèi)中是最常見(jiàn)的黃色葡萄球菌,但在小鼠中很少能檢測到,在大鼠中則幾乎完全不存在。相應的,大小鼠中最常見(jiàn)的C88也未見(jiàn)有感染動(dòng)物設施內工作人員的報道。這說(shuō)明金黃色葡萄球菌從嚙齒類(lèi)動(dòng)物傳播到人是不易發(fā)生的。
從實(shí)驗室小鼠、大鼠中分離到的金黃色葡萄球菌較少攜帶免疫逃避基因IEC及編碼人類(lèi)特異性毒力因子的MGE基因,同時(shí),由于實(shí)驗小鼠中通常不會(huì )使用抗生素,細菌消除了保持抗藥性基因的壓力,因此小鼠金黃色葡萄球菌對青霉素的耐藥率低于人類(lèi)菌株,且大多數小鼠和大鼠分離株缺乏氨芐西林耐藥性,這些都顯示這些菌株長(cháng)期適應了嚙齒動(dòng)物宿主。
在嚙齒類(lèi)實(shí)驗動(dòng)物和人群中分離的金黃色葡萄球菌的這些差異提示,盡管金黃色葡萄球菌有從人傳播到實(shí)驗嚙齒類(lèi)動(dòng)物的風(fēng)險,但是實(shí)驗動(dòng)物中所流行的細菌主要來(lái)自動(dòng)物群體內部。
臨床癥狀
健康且免疫功能健全的嚙齒動(dòng)物和兔的皮膚、黏膜或腸道中即使可以檢出金黃色葡萄球菌但一般也都是無(wú)癥狀的,這種隱性感染占絕大多數,這也是這次國標修訂過(guò)程中將該菌從必檢項調整為必要時(shí)檢測項的主要原因之一。
在出現臨床癥狀的嚙齒類(lèi)動(dòng)物中,最經(jīng)常出現的癥狀包括潰瘍性皮炎、創(chuàng )傷性皮炎、皮膚膿腫、包皮腺膿腫、子宮內膜炎等。出現臨床癥狀的兔可表現為皮下膿腫、乳腺炎、足皮炎和敗血癥等。

圖1 裸鼠葡萄球菌感染導致出現面部膿腫、眼眶腫脹、皮屑
其他葡萄球菌
2023年1-6月,蘇州西山生物檢測部在對客戶(hù)送檢的出現皮屑、脫毛、皮膚腫脹、破潰、結膜炎等癥狀的實(shí)驗小鼠樣本的鑒定檢測過(guò)程中發(fā)現,21份送檢樣本有20份是葡萄球菌感染引起。其中松鼠葡萄球菌陽(yáng)性12例,木糖葡萄球菌陽(yáng)性11例,其次為緩慢葡萄球菌(4例)、科氏葡萄球菌(3例)、尼泊爾葡萄球菌(2例)、頭葡萄球菌(1例)和金黃色葡萄球菌(1例),見(jiàn)圖2。這說(shuō)明,目前在臨床上,金黃色葡萄球菌不應是我們唯一關(guān)注的葡萄球菌,多種葡萄球菌都可能感染嚙齒類(lèi)實(shí)驗動(dòng)物并可能發(fā)展為有癥狀的感染性疾病,其中小部分會(huì )造成動(dòng)物群體大規模發(fā)病。CharlesRiver 2003-2020年的檢測數據也顯示,小鼠相關(guān)樣本的PCR檢測中發(fā)現了木糖葡萄球菌有高達51.8%(n=1426)的檢出。木糖葡萄球菌、松鼠葡萄球菌等定植并導致嚙齒類(lèi)實(shí)驗動(dòng)物出現皮膚病變也多有報道。因此實(shí)驗動(dòng)物在出現疑似傳染性臨床疾病后應及時(shí)檢測鑒定,如果是由于葡萄球菌感染導致,應對這些菌株做進(jìn)一步分析確認其株型,對那些已經(jīng)確認的高毒力株型或已經(jīng)造成大量動(dòng)物發(fā)病的,應積極采取措施,將其徹底從自己的設施中清除。

圖2.葡萄球菌在小鼠皮膚感染病例中檢出情況
檢測
目前采用較多的檢測方法為細菌分離培養法以及生化鑒定。同時(shí),PCR方法進(jìn)行核酸檢測也被越來(lái)越廣泛地應用于篩查檢測和分型檢測。此外,MALDI-TOF MS質(zhì)譜法直接對微生物的蛋白質(zhì)混合物進(jìn)行分析,能夠快速鑒定菌種,也是目前臨床上常用的鑒定方法。
圖3.葡萄球菌在血瓊脂平板上的菌落形態(tài)
預防和控制
在原來(lái)沒(méi)有金黃色葡萄球菌的屏障設施中,后期可能會(huì )通過(guò)一些偶然因素導致細菌的引入,從Charles River五個(gè)屏障設施的回顧性數據顯示,一個(gè)金黃色葡萄球菌陰性屏障設施要10個(gè)月到4年的時(shí)間才可能變?yōu)殛?yáng)性,一旦引入,如果不加以監測排除,則細菌會(huì )很容易長(cháng)期定植并穩定傳播給后代,但是在不同籠子之間的傳播效率則是不一定的。可以肯定的是獨立通風(fēng)籠具的使用、良好的衛生措施和規范的飼養管理操作可以有效阻斷傳播,降低感染率。
因此對于那些決定要將金黃色葡萄球菌保留在自己的監測清單的設施而言,就需要對引入的動(dòng)物和維持的動(dòng)物進(jìn)行監測并及時(shí)剔除感染動(dòng)物,同時(shí)加強工作人員個(gè)人防護措施,還需加強對環(huán)境的清潔和消毒。金黃色葡萄球菌對多數消毒劑都敏感,但是對干燥環(huán)境有抗性。
對研究的影響
大多數情況下,金黃色葡萄球菌感染不會(huì )影響研究,這是本次國標修訂將該菌從必檢項調整為必要時(shí)檢測項的另一主要原因。不過(guò)金黃色葡萄球菌的定植啟動(dòng)了小鼠免疫系統,誘導了許多對金黃色葡萄球菌蛋白特異性的IgG免疫應答,這將影響葡萄球菌相關(guān)的感染實(shí)驗和疫苗研究,因此做這類(lèi)研究時(shí)還是應使用不攜帶該菌的動(dòng)物。
參考資料:
1.《全國臨床檢驗操作規程 第4版》
2.《獸醫微生物學(xué) 第6版》
3. GOZALO A S, HOFFMANN V J, BRINSTER L R, et al. Spontaneous Staphylococcus xylosus infection in mice deficient in NADPH oxidase and comparison with other laboratory mouse strains[J]. J Am Assoc Lab Anim Sci, 2010, 49(4):480-486.
4. KENGKOOM K, AMPAWONG S. Staphylococcus sciuri associated to subcutaneous abscess and dermatitis in ICR mouse[J]. Arq Bras Med Vet Zootec, 2017, 69(1):117-122.
5. Theresa M Albers, Kenneth S Henderson,Guy B Mulder, et al. Pathogen Prevalence Estimates and Diagnostic Methodology Trends in Laboratory Mice and Rats from 2003 to 2020[J]. J Am Assoc Lab Anim Sci, 2023, 62(3):229-242.
6. Daniel S ,Dorothee G ,TrübePatricia,etal.Laboratory Mice Are Frequently Colonized with Staphylococcus aureus and Mount a Systemic Immune Response—Note of Caution for In vivo Infection Experiments[J].Frontiers in Cellular & Infection Microbiology, 2017, 7:152-.DOI:10.3389/fcimb.2017.00152.
7. RaafatD ,Mrochen D M , Al'Sholui F ,et al.Molecular Epidemiology of Methicillin-Susceptible and Methicillin-Resistant Staphylococcus aureus in Wild, Captive and Laboratory Rats: Effect of Habitat on the Nasal S. aureus Population.[J].Toxins (Basel), 2020(2).
8. Hermans K , Devriese L A , Haesebrouck F .Rabbit staphylococcosis: difficult solutions for serious problems[J].Veterinary Microbiology, 2003, 91(1):57-64.
9. MALDI-TOF MS質(zhì)譜技術(shù)在微生物學(xué)研究中的應用
10. 李宗良,賴(lài)春顏,梁敏鋒,等.葡萄球菌屬的臨床分布與耐藥性分析[J].中華醫院感染學(xué)雜志, 2015, 25(12):3.